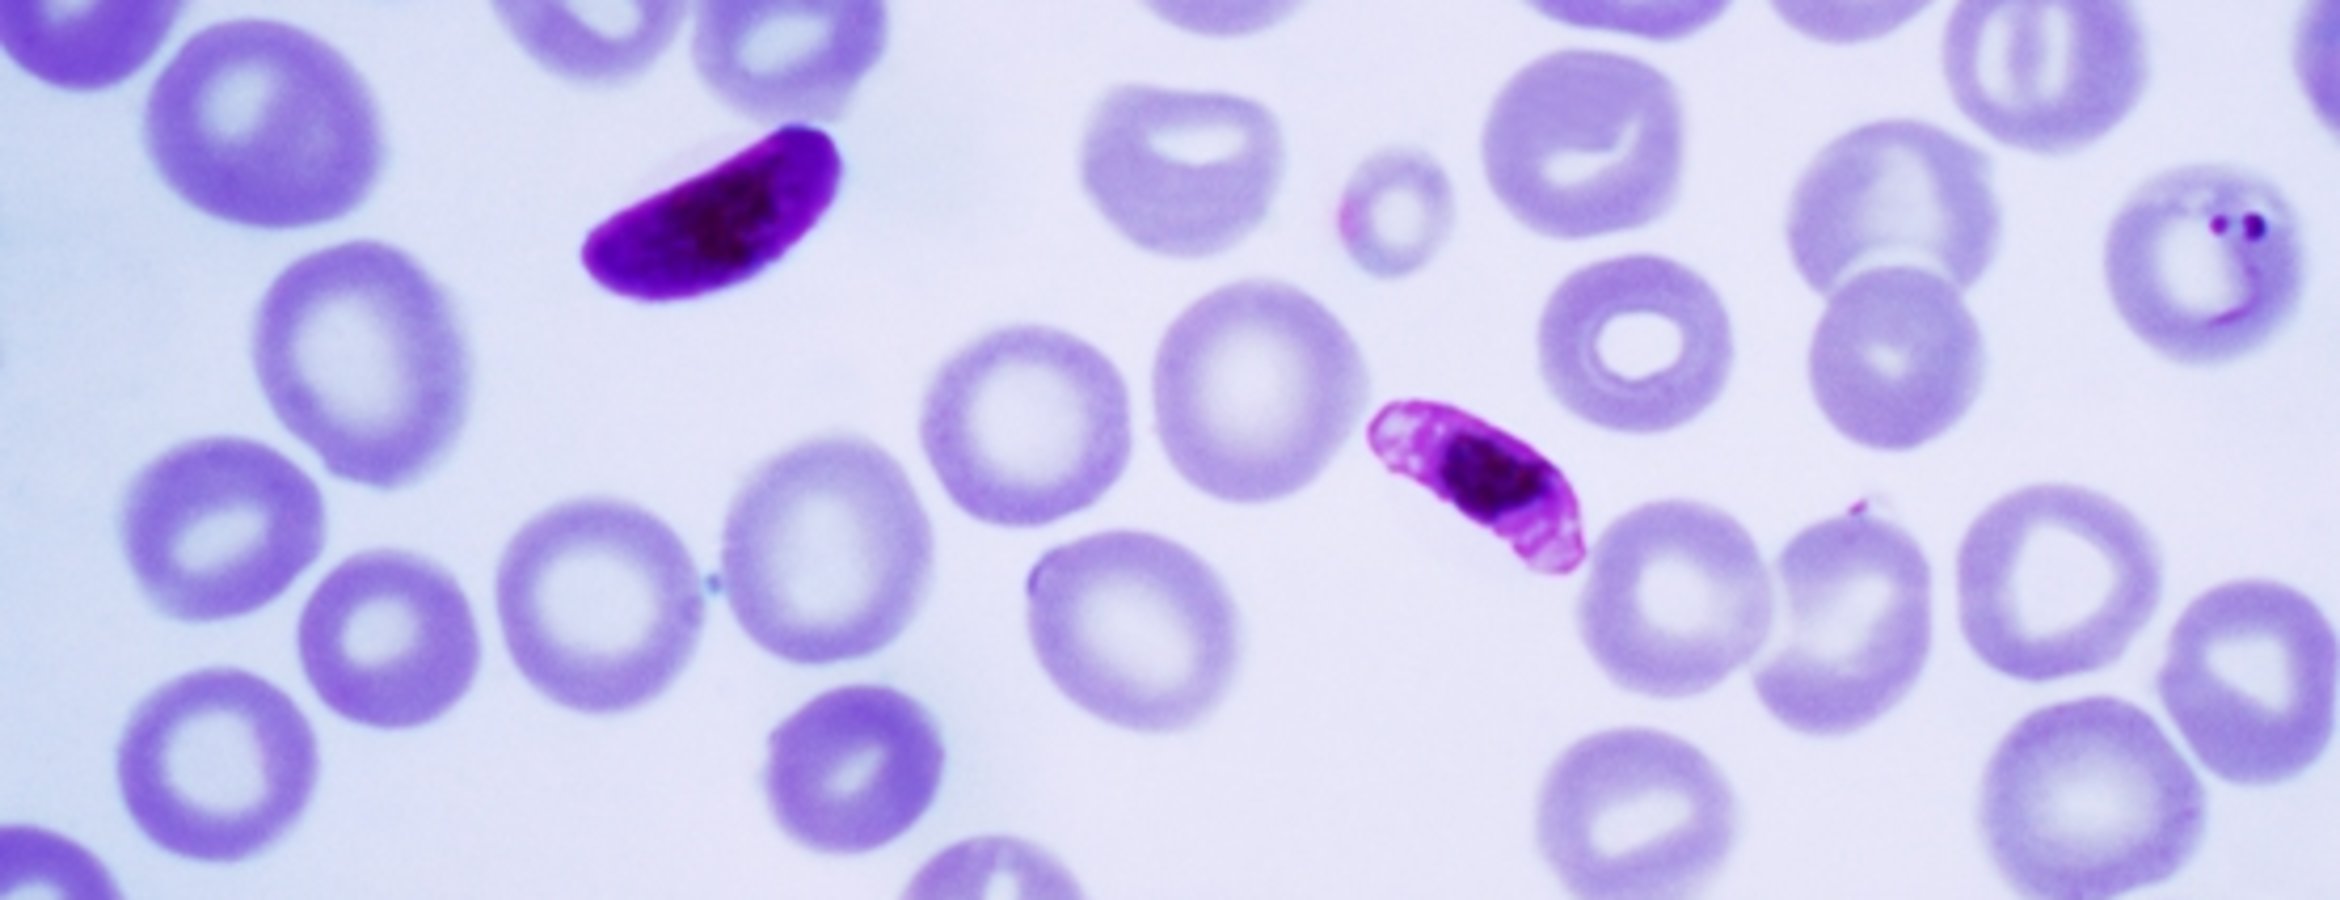

Sıtmayla mücadelede geliştirilen aşı ilk kez Fildişi Sahili'nde uygulanmaya başlandı
Sıtma salgınına karşı üretilen ve "R21/Matrix-M" adı verilen yeni tür aşının ilk kez Fildişi Sahili'nde uygulanmaya başlandığı bildirildi.
Oxford Üniversitesinden Adrian Hill, basına yaptığı açıklamada, aşının, 2 yaş altı yaklaşık 250 bin çocuğa uygulanacağını belirterek, "R21/Matrix-M" olarak bilinen 3 dozluk aşının Dünya Sağlık Örgütü (DSÖ) tarafından onaylandığını ifade etti.
Geliştirdikleri yeni aşının ilk kez Batı Afrika ülkelerinden Fildişi Sahili'nde uygulandığı bilgisini paylaşan Hill, Fildişi Sahili'ndeki uygulamanın, sıtma kontrolünde yeni bir dönemin başlangıcına işaret ettiğini vurgulayarak, aşının yakında Afrika'daki tüm ülkelerce kullanılabilir olmasını umduklarını kaydetti.
Fildişi Sahili Sağlık Bakanı Pierre Demba, sıtmaya karşı çocukları korumada kararlı olduklarını dile getirerek, "Onlar ülkemizin geleceğidir." dedi.
DSÖ, sıtmaya karşı geliştirilen ilk aşı olan "RTS,S"yi 2021'de onaylarken, "R21/Matrix-M" adı verilen ikinci aşıyı da geçen yıl önerdiklerini duyurmuştu.
Yasal Uyarı: Yayınlanan köşe yazısı/haberin tüm hakları Turkuvaz Medya Grubu'na aittir. Kaynak gösterilse dahi köşe yazısı/haberin tamamı özel izin alınmadan kullanılamaz.
Ancak alıntılanan köşe yazısı/haberin bir bölümü, alıntılanan habere aktif link verilerek kullanılabilir. Ayrıntılar için lütfen tıklayın.







